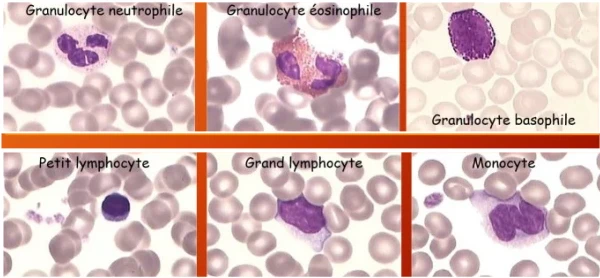

- bts
- Terminale STL
- dut
- travaux pratiques
- leçon
- élève
- étudiant
- laboratoire
- classe
Frottis sanguin et coloration au MGG
Diaporama présentant les aspects théorique et pratique de la réalisation des frottis sanguins et de leur coloration au May Grünwald Giemsa

Ce diaporama peut être utilisé en préliminaire ou lors d'une séance de travaux pratiques
Il peut être facilement séparé en trois parties selon l'avancement des manipulations.
Logo et photos du diaporama Crédits : Catherine POCHET
auteurs :
Equipe pédagogique (Jean MOULIN ANGERS)
Mots clés :
Information(s) pédagogique(s)
Niveau :
bts, Terminale STL, dut
Type pédagogique :
travaux pratiques, leçon
Public visé :
élève, étudiant
Contexte d'usage :
laboratoire, classe
Référence aux programmes :
Classe de Terminale STL BGB
Classe de Section de BTS Biologie Médicale, BioAC, DUT, DETAB
Classe de Section de BTS Biologie Médicale, BioAC, DUT, DETAB
Fichier joint
présentation .pptx accessible grâce au logiciel PowerPoint de Microsoft Office ou au logiciel gratuit de la série Open Office